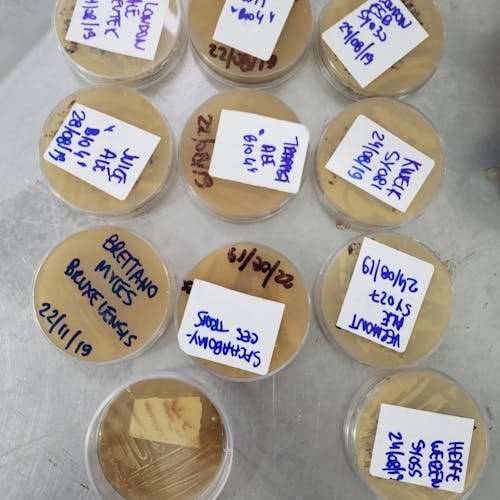

Mestre cervejeiro por um dia: Crie sua própria cerveja artesanal com especialistas!
Sinnatrah Cervejaria Escola
Destinada para entusiastas da cerveja que querem saber mais sobre o tema ou planejam começar a produzir suas próprias cervejas, essa experiência é uma vivência de um dia, com direito a muito conhecimento, diversão e claro, a possibilidade de se sentir um mestre cervejeiro por algumas horas!
Durante um dia inteiro os participantes aprenderão como produzir sua própria cerveja artesanal em casa, orientados por especialistas com uma abordagem que vai da teoria à prática envolvendo todas as etapas, da moagem do malte até o envase de uma cerveja pronta.
Quem comanda a experiência com toda expertise é a Cervejaria Sinnatrah que fica em São Paulo. A didática é uma mistura de teoria e prática para fabricação da bebida durante o período de aula.
O que vou aprender durante a experiência?
A história e os estilos de cerveja, ingredientes (malte, lúpulo, levedura, água), equipamentos cervejeiros e modo de preparo completo de uma leva de 20 litros da bebida. São acompanhados em detalhes procedimentos fundamentais para a fabricação de uma cerveja de qualidade como sanitização de equipamentos, mostura, clarificação, filtração do mosto, fervura, dosagem de lúpulo, resfriamento do mosto, dosagem de levedura, fermentação, maturação, carbonatação e envase.
Não é necessário conhecimento prévio sobre o assunto. Fazer cerveja em casa pode se tornar um hobby acessível e interessante que reúne amigos, alivia a mente e enche barrigas! É possível fazer cervejas excelentes no fogão de casa e durante a experiência os alunos serão orientados sobre a escolha de equipamentos e das primeiras receitas para produzir a sua cerveja!
A Sinnatrah
A Sinnatrah é uma cervejaria-escola que oferece cursos e experiências de cerveja desde 2009 e tornou-se referência no ensino e cultura cervejeira. A sede abriga também um Brew Shop que é um ponto de encontro de alunos e cervejeiros caseiros.
A cervejaria-escola nasceu da paixão de dois biólogos pela cerveja e seu processo produtivo. Rodrigo e Alexandre fizeram sua primeira cerveja caseira em 2004, batizada de Sinnatrah em homenagem ao gato que morava na casa. Também é uma referência ao modo “artesanal” de controle de pragas nas cervejarias medievais.
O que está incluso: Apostila, certificado, café da manhã, beer break, R$35,00 em voucher de desconto para compra na loja do local, e a garrafa da própria cerveja que produziu pra levar pra casa!
Horário: das 10h às 17h
Agenda: Consultar próximas datas no site da Sinnatrah - link logo abaixo dos vídeos.
Contato: (11) 3862-5421